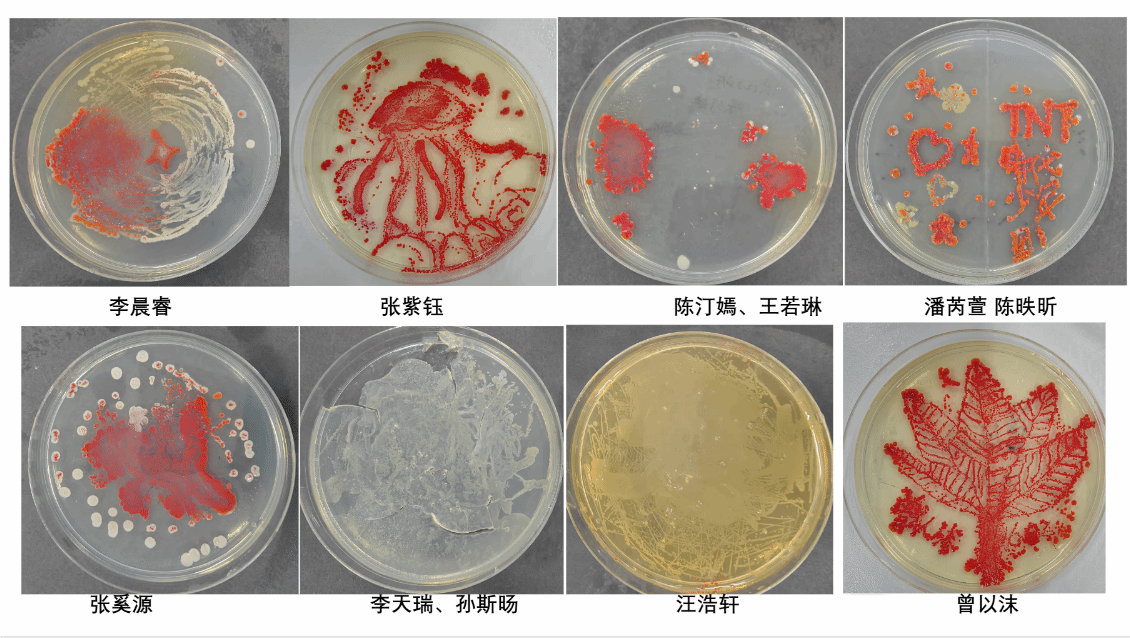
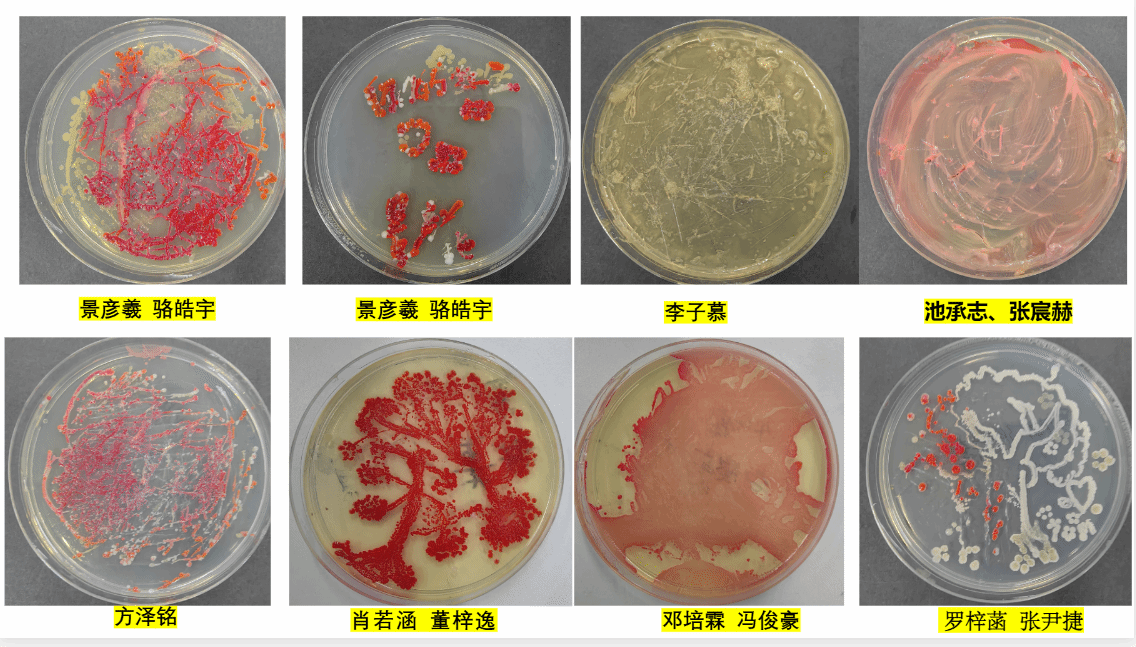
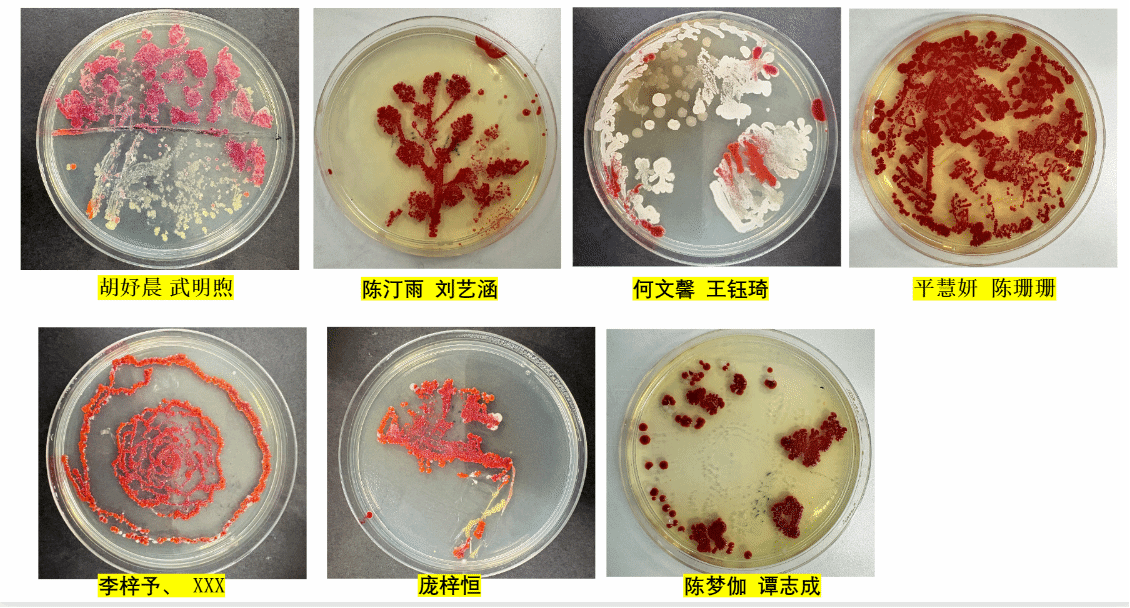
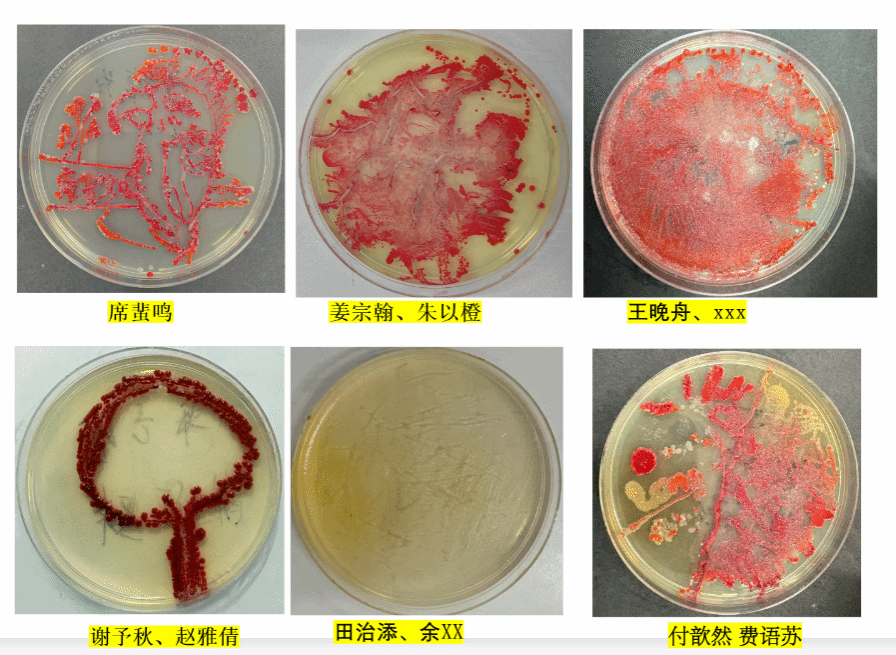
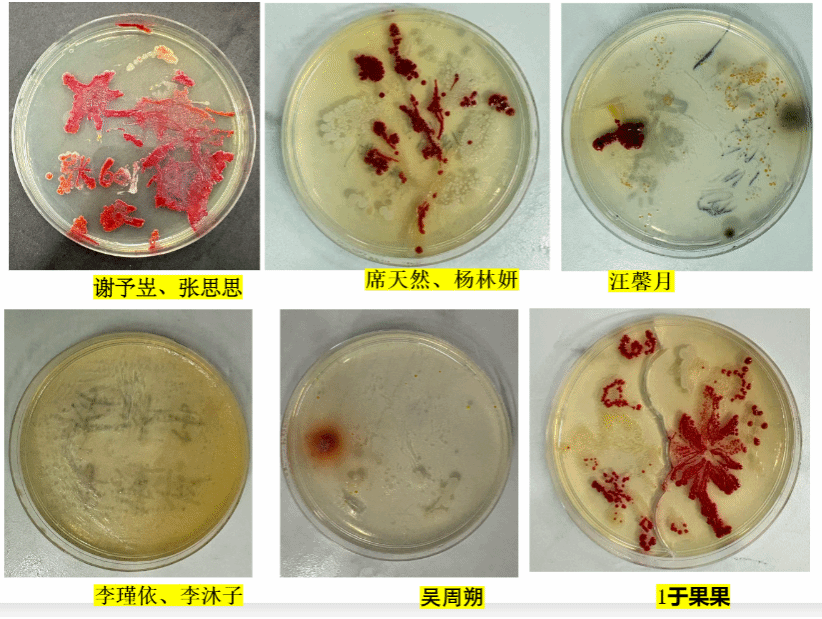

(通讯员:吕霞)当戴着帝王冠冕的微生物形象出现在PPT上时,六(1)、六(2)班的孩子们的头脑里炸开了好奇的“小问号”。11月26日下午,中国地质大学(武汉)地质微生物与环境全国重点实验室的黄柳琴教授带来的《“菌”临天下——微生物改造地球记》科普课,把35亿年的地球史,变成了一场微观世界的“创世传奇”。

微观“拓荒者”:地球的初代“改造师”
“地球多少岁?早期像什么?”黄教授的提问刚落,PPT上“火球地球”的炽热画面,和如今蔚蓝星球形成鲜明对比——而这场巨变的“幕后操盘手”,竟是肉眼难见的微生物。
“它们是地球最早的‘拓荒者’!”黄教授笑着揭秘:35亿年前,微生物就扎根在没有氧气、满是毒气的“炼狱”地球,靠着“耐冻耐热(-12℃到120℃都能活)、无氧也能生存、啃无机物当饭”的硬核本领,一“霸”就是30多亿年。
当讲到蓝藻是“造氧工程师”时,孩子们瞪圆了眼睛:24亿年前第一次氧气爆发,让大气氧含量从0爬向2%;8亿年前第二次“供氧”,直接把地球“装修”成适合复杂生命生存的家园。“原来我们呼吸的每一口氧,都是微生物攒了几十亿年的‘礼物’!”所有在场的同学们忍不住惊叹。

动手“画”细菌:微观世界里的浪漫创作
最让人期待的“微生物作画”环节,把课堂推向了高潮。戴上手套的孩子们,小心翼翼地用接种环蘸取不同菌种,在无菌培养皿里勾勒线条:有的画起小树,有的设计星空,有的创作了专属班级徽章,仿佛在微观画布上,挥洒着天马行空的想象力。
“手要稳,轻轻点——”黄教授在一旁指导,看着培养皿里的“线条”慢慢晕开,孩子们的眼睛里满是雀跃:“等菌落长出来,我的画会变成彩色的吗?”“这是我第一次用细菌当‘颜料’,太酷了!”

少年感想:微小的力量,能改天换地
活动结束后,孩子们的感想里,写满了对微生物的“新认知”:






从“地球改造师”的硬核知识,到“微生物作画”的浪漫实践,这堂由民盟地大委员会科普组筹划的科普课,让微观世界的伟大,悄悄在少年心中埋下了敬畏与好奇的种子。那些藏在培养皿里的彩色菌落,那些写在纸上的真挚文字,都是科学梦想发芽的声音——愿这份热爱,能陪他们在探索之路上,走得更远、更精彩。(编辑:吴瑛婷 审核:罗红兵)